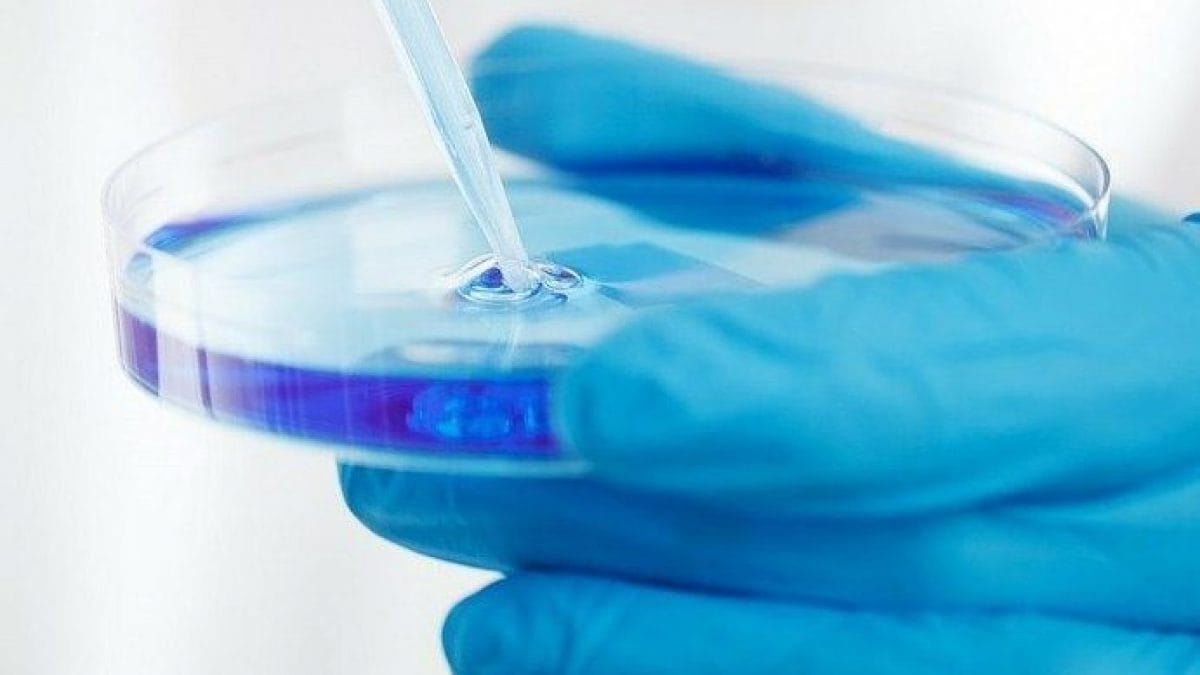

Il prossimo 13 febbraio in Svizzera i cittadini si esprimeranno con un voto popolare per vietare gli esperimenti sugli animali e sugli esseri umani. Gli studi che li vedono come cavie sono consentiti da protocolli scientifici che, ad oggi, fanno parte dei percorsi di ricerca necessari per poi autorizzare alcuni trattamenti specifici.
La normativa svizzera prevede di impiegare solo il numero di animali strettamente necessario al lavoro, chiedendo di arrecare loro la minore sofferenza possibile. L’iniziativa popolare propone di vietare in toto tutte le sperimentazioni e di evitare l’importazione di prodotti sviluppati all’estero e che abbiano previsto la loro uccisione. Inoltre, chiede che la ricera sia condotta senza impiegare animali, ricevendo lo stesso sostegno statale che è accordato oggi alla ricerca che se ne avvale.
La proposta popolare, nel caso in cui dovesse passare, allarga anche la propria azione esigendo il divieto di sperimentazione sugli esseri umani. Ma la politica già ha detto come la pensa. Il Consiglio degli Stati (con 42 voti contrari e 2 astensioni) e il Consiglio nazionale (con 195 voti contrari, nessun sì e nessuna astensione), hanno già espresso il loro secco “no” all’iniziativa. Il Comitato che lo ha proposto, invece, ritiene inammissibile condurre esperimenti «abusando di animali e persone che non sono in grado di esprime la propria volontà. Nessun animale o essere umano – aggiunge – può fornire previsioni attendibili per un altro essere vivente».
In Svizzera nel 2020 sono stati impiegati 556.107 animali da laboratorio. Numeri in calo rispetto ai 572.069 dell’anno precedente (-2,8) e in ulteriore diminuzione dal 2015 (-18%). Lo scorso anno 104.075 esemplari sono stati usati per la lotta al cancro, 16.042 per i trattamenti di patologie cardiovascolari, 67.944 per i disturbi nervosi e mentali. Tredici sono stati invece gli studi contro Sars Cov-2 che hanno visto l’impiego di 1.328 animali da laboratorio.